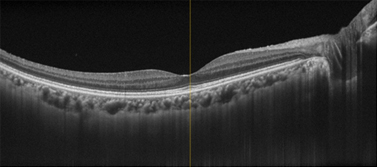
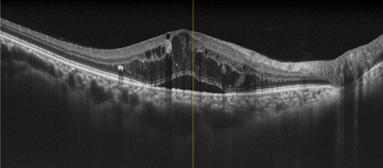

糖尿病網膜症なし
糖尿病網膜症なし
15年前後で網膜症が発症する場合が多いのですが、血糖コントロールが不十分だと5~10年で網膜症が発症します。自覚症状がなくても定期的な眼底検査を受けることが大切です。




15年前後で網膜症が発症する場合が多いのですが、血糖コントロールが不十分だと5~10年で網膜症が発症します。自覚症状がなくても定期的な眼底検査を受けることが大切です。

血管の所々に障害が現れ始め、毛細血管瘤、点状・斑状出血、硬性白斑などが現れます。

血管が詰まって、網膜の一部に血液が流れていない虚血部分が生じてきた段階で、そのまま放置すれば次の増殖網膜症に進行します。軟性白斑、血管閉塞、静脈異常、網膜浮腫などが起きてきます。

虚血部分に酸素や栄養を送り込もうと、新生血管が網膜の表面や硝子体に伸びてきます。薄い膜状の増殖膜が形成されたり、新生血管が破れることで硝子体出血、増殖膜が網膜を牽引することで網膜剥離が生じます。

視力、眼圧、精密眼底検査を病期と病状に応じた頻度で行います。
網膜血管の異常を正確に把握するために、造影剤を静脈注射した後、眼底カメラで撮影する血管造影検査です。治療方針の決定に役立ちます。

網膜の層構造を断面的に観察できます。
黄斑浮腫(網膜のむくみ)の状態がわかります。

光干渉断層画像から、造影剤を使わず非侵襲的に血管構造を画像化することができるようになりました。さらに層別に表示することができます。

新生血管が発生してくるのを予防したり、すでに発生している新生血管を退縮させたりする治療です。増殖前網膜症、増殖網膜症に行います。
糖尿病黄斑症に対して、浮腫の強い部分に局所光凝固や閾値下レーザーを行うこともあります。
糖尿病黄斑症に対して、VEGF阻害剤の硝子体注射を行います。視力や眼底の状態が安定するまで必要に応じて注射します。再発時には、再度注射を行います。
糖尿病黄斑症に対して、眼球の外側や、硝子体内に注射します。
増殖網膜症で硝子体出血を除去したり、網膜剥離を元に戻したりする手術です。
糖尿病黄斑症の治療のために行うこともあります。

糖尿病は、内科も眼科も受診を中断しないことが一番大切です!
糖尿病網膜症は、進行しても自覚症状が無いこともあります。網膜症がないうちから定期受診を続け、網膜症が生じたら、適切な時期に適切な治療を続けていくことで、大切な視力を守りましょう。